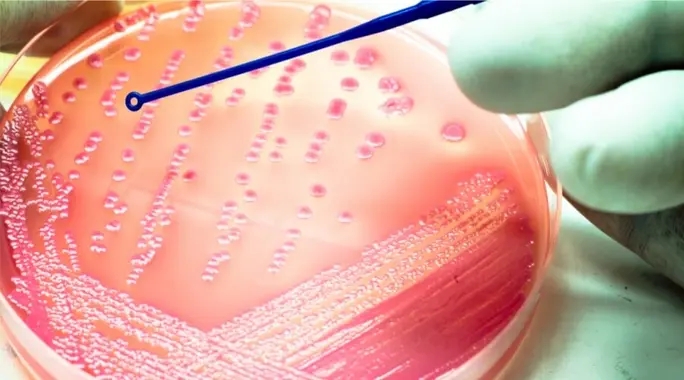

تُعدّ العدوى البكتيرية تحديًا صحيًا عالميًا، ويتوقف علاجها الفعّال على التشخيص الدقيق والسريع. لكن كيف يتعرف الأطباء على هذه الكائنات الدقيقة المسببة للأمراض؟
لحسن الحظ، تطورت طرق تشخيص البكتيريا بشكل كبير، لتشمل تقنيات متنوعة تمكّن المختصين من تحديد نوع البكتيريا بدقة واختيار العلاج الأمثل. في هذا المقال، سنستعرض أبرز هذه الطرق، بدءًا من الفحص المجهري وصولًا إلى التحاليل الجينية المتقدمة، ونتعرف على الفروقات الرئيسية بينها.
جدول المحتويات
- لماذا يُعد تشخيص البكتيريا أمرًا حيويًا للعلاج الفوري؟
- مراحل تشخيص العدوى البكتيرية الأولية
- الفحص المجهري المباشر: نظرة أولية على البكتيريا
- الزراعة البكتيرية: تنمية الكائنات الدقيقة للتعرف عليها
- الاختبارات المناعية: الكشف عن رد فعل الجسم أو أجزاء البكتيريا
- الاختبارات الجينية: الدقة في تحديد المادة الوراثية
- اختبار حساسية المضادات الحيوية: تحديد العلاج الفعال
- مقارنة طرق تشخيص البكتيريا: إيجابيات وسلبيات
- الخاتمة
لماذا يُعد تشخيص البكتيريا أمرًا حيويًا للعلاج الفوري؟
تتسبب البكتيريا في مجموعة واسعة من الأمراض المعدية التي تتطلب تدخلًا سريعًا وفعالًا. إن معرفة نوع البكتيريا المسببة للمرض ليس مجرد فضول علمي، بل هو خطوة حاسمة لتقديم العلاج المناسب وتجنب المضاعفات الخطيرة.
يسهم التشخيص الدقيق في اختيار المضادات الحيوية الصحيحة، مما يقلل من مقاومة البكتيريا للأدوية ويضمن شفاء المريض بشكل أسرع. كما أن السرعة في التشخيص تلعب دورًا محوريًا في منع انتشار العدوى، خاصة في الحالات الوبائية.
مراحل تشخيص العدوى البكتيرية الأولية
عادةً ما تبدأ عملية تشخيص البكتيريا بأخذ عينة من المنطقة المصابة في الجسم. قد تكون هذه العينة من الدم أو البول أو البراز أو سوائل الجسم الأخرى أو حتى الأنسجة، وذلك بناءً على نوع العدوى المشتبه بها وموقعها.
بمجرد الحصول على العينة، تُرسل إلى المختبر حيث يتم إجراء مجموعة من الفحوصات والتحاليل لتحديد وجود البكتيريا ونوعها وخصائصها المختلفة.
الفحص المجهري المباشر: نظرة أولية على البكتيريا
يُعد الفحص المجهري المباشر واحدًا من أسرع طرق تشخيص البكتيريا وأكثرها شيوعًا. يقوم المختصون بتحضير شريحة من العينة وفحصها تحت المجهر، مما يكشف عن وجود الكائنات الدقيقة وشكلها وحجمها الأولي.
تُعالج معظم العينات بصبغات خاصة تُلوّن البكتيريا وتجعلها أكثر وضوحًا. هذه الصبغات تساعد في تمييز البكتيريا عن الخلايا البشرية الأخرى وفي بعض الأحيان تعطي فكرة مبدئية عن نوعها.
صبغة غرام ودورها في تصنيف البكتيريا
تُعد صبغة غرام من أشهر الصبغات المستخدمة في الفحص المجهري. وهي صبغة بنفسجية تُستخدم كخطوة أولية لتصنيف البكتيريا إلى فئتين رئيسيتين بناءً على تركيب جدارها الخلوي:
- بكتيريا إيجابية الغرام: تظهر باللون الأزرق أو البنفسجي لأنها تحتفظ بالصبغة.
- بكتيريا سالبة الغرام: تظهر باللون الأحمر أو الوردي لأنها لا تحتفظ بالصبغة وتصبغ بصبغة مضادة.
يعطي هذا التصنيف الأولي للأطباء فكرة سريعة عن مجموعة المضادات الحيوية التي قد تكون فعالة، حتى قبل تحديد النوع الدقيق للبكتيريا.
الزراعة البكتيرية: تنمية الكائنات الدقيقة للتعرف عليها
في كثير من الأحيان، يكون عدد البكتيريا في العينة قليلًا جدًا بحيث لا يمكن رؤيتها بوضوح تحت المجهر. هنا يأتي دور الزراعة البكتيرية، وهي طريقة تسمح بتكثير البكتيريا في بيئة مختبرية للوصول إلى عدد كافٍ لتحديد هويتها.
توضع العينة في أطباق أو أنابيب اختبار تحتوي على أوساط غذائية خاصة توفر الظروف المثالية لنمو البكتيريا المرغوبة، مع مواد أخرى قد تثبط نمو البكتيريا غير المرغوبة. تستغرق هذه العملية عادةً من يوم إلى عدة أيام، وقد تطول لأسابيع في بعض الحالات.
الاختبارات المناعية: الكشف عن رد فعل الجسم أو أجزاء البكتيريا
عندما لا يمكن رؤية بعض أنواع البكتيريا بالمجهر أو زراعتها بسهولة، تلجأ المختبرات إلى الاختبارات المناعية. هذه الاختبارات تكشف عن مكونات محددة تتعلق بالبكتيريا أو برد فعل الجهاز المناعي تجاهها.
الكشف عن الأجسام المضادة
تُعرف الأجسام المضادة بأنها بروتينات ينتجها الجهاز المناعي للشخص كاستجابة لوجود البكتيريا. يكشف هذا النوع من الاختبارات عن هذه الأجسام المضادة في الدم، مما يشير إلى أن الجسم قد تعرض للعدوى.
لكن يجب الأخذ في الاعتبار أن الجسم قد يحتاج إلى أسابيع لإنتاج كمية كافية من الأجسام المضادة، وقد تبقى هذه الأجسام في الجسم لفترة طويلة حتى بعد الشفاء، لذا فإن وجودها لا يعني بالضرورة وجود عدوى نشطة حاليًا.
الكشف عن المستضدات البكتيرية
المستضدات هي جزيئات أو أجزاء من البكتيريا نفسها تسبب استجابة مناعية في الجسم. يمكن للاختبارات المناعية أن تكشف مباشرة عن وجود هذه المستضدات في العينة، مما يدل على وجود البكتيريا النشطة في الجسم.
الاختبارات الجينية: الدقة في تحديد المادة الوراثية
تمثل الاختبارات الجينية قفزة نوعية في طرق تشخيص البكتيريا، حيث تستهدف الكشف عن المادة الوراثية (الحمض النووي أو RNA) الخاصة بالبكتيريا. تتميز هذه الاختبارات بدقتها العالية وقدرتها على تحديد أنواع البكتيريا التي يصعب اكتشافها بالطرق التقليدية.
تقنية تفاعل البوليميراز المتسلسل (PCR)
تُعد تقنية PCR من أبرز الاختبارات الجينية. تقوم هذه التقنية بإنتاج ملايين النسخ من جزء معين من الحمض النووي للبكتيريا، حتى لو كانت الكمية الأصلية قليلة جدًا. هذه العملية تضخم المادة الوراثية، مما يجعل اكتشاف البكتيريا وتحديد هويتها أسهل وأكثر حساسية.
اختبارات جزيئية أخرى لتحديد البكتيريا
بالإضافة إلى PCR، توجد اختبارات جزيئية أخرى يمكنها التعرف على مواد فريدة تنتجها البكتيريا، مثل إنزيمات معينة، أو بروتينات، أو أحماض دهنية مميزة. هذه الاختبارات توفر طرقًا إضافية لتحديد البكتيريا بدقة، خاصة تلك التي تمتلك بصمات جزيئية فريدة.
اختبار حساسية المضادات الحيوية: تحديد العلاج الفعال
بعد تحديد نوع البكتيريا المسببة للعدوى، تأتي الخطوة الأهم: معرفة المضادات الحيوية التي ستكون فعالة ضدها. على الرغم من أن الأطباء لديهم فكرة عامة عن الأدوية المناسبة لكل نوع، إلا أن البكتيريا تتطور باستمرار وتكتسب مقاومة للمضادات الحيوية.
يتم إجراء اختبار الحساسية عن طريق تعريض البكتيريا المعزولة لأنواع مختلفة من المضادات الحيوية في المختبر. هذا الاختبار يحدد أي الأدوية يمكن أن يوقف نمو البكتيريا أو يقتلها، مما يوجه الطبيب لاختيار العلاج الأكثر فعالية للمريض.
مقارنة طرق تشخيص البكتيريا: إيجابيات وسلبيات
كل طريقة من طرق تشخيص البكتيريا تمتلك مزاياها وعيوبها الخاصة، مما يجعل اختيار الأسلوب الأنسب يعتمد على نوع العدوى المشتبه بها وسرعة الحاجة للتشخيص والتكاليف المتاحة. إليك ملخصًا للفروقات الرئيسية:
- الفحص المجهري المباشر:
- الإيجابيات: سريع ويعطي نتائج فورية، مفيد كخطوة أولية.
- السلبيات: يتطلب وجود عدد كافٍ من البكتيريا وحجم واضح، لا يميز كل الأنواع، بعض البكتيريا لا يمكن رؤيتها بسهولة.
- الزراعة البكتيرية:
- الإيجابيات: طريقة دقيقة جدًا لتحديد نوع البكتيريا، تسمح بإجراء اختبارات الحساسية للمضادات الحيوية.
- السلبيات: تستغرق وقتًا قد يصل إلى عدة أيام أو أسابيع، بعض البكتيريا لا يمكن زراعتها.
- الاختبارات المناعية:
- الإيجابيات: عالية الدقة في تحديد نوع البكتيريا، مناسبة للبكتيريا التي يصعب زراعتها.
- السلبيات: قد تستغرق أسابيع حتى يكوّن الجسم أجسامًا مضادة كافية، وجود الأجسام المضادة لا يعني بالضرورة عدوى نشطة.
- الاختبارات الجينية:
- الإيجابيات: دقيقة للغاية، مناسبة عند صعوبة الزراعة، سريعة نسبيًا.
- السلبيات: قد تكون باهظة الثمن ولا تتوفر في كل المختبرات، قد لا تكشف بالضرورة عن الجينات المسؤولة عن مقاومة الأدوية.
الخاتمة
يُعد التشخيص الدقيق والسريع للعدوى البكتيرية حجر الزاوية في العلاج الفعال والوقاية من مضاعفاتها. مع التطور المستمر في طرق تشخيص البكتيريا، أصبح الأطباء يمتلكون أدوات قوية لتحديد هوية الميكروب المسبب للمرض بدقة، مما يتيح لهم اختيار العلاج المناسب بسرعة وفعالية، ويساهم في الحفاظ على صحة المجتمع وسلامته.